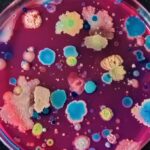
Logran un cóctel bacteriano para restaurar suelos contaminados por plásticos

Carmen Callao
Abogada
Mendo & Callao Legal
Esta normativa establece que los residuos se deben aplicar a los suelos agrarios exclusivamente con el fin de producir un beneficio a la agricultura o una mejora ecológica de los mismos.
En el BOE de 29 de diciembre de 2022 se publicó el Real Decreto 1051/2022, de 27 de diciembre, por el que se establecen normas para la nutrición sostenible en los suelos agrarios y en cuyos artículos 14 y 15 regula los residuos valorizables y la aplicación de los residuos valorizables a los suelos agrarios.
Este Real Decreto establece que los residuos se deben aplicar a los suelos agrarios exclusivamente con el fin de producir un beneficio a la agricultura o una mejora ecológica de los mismos. Por ello deberán cumplir las disposiciones que les sean de aplicación para su valorización como operación R1001 “Valorización de residuos en suelos agrícolas y en jardinería”, de acuerdo con la Ley 7/2022, de 8 de abril, las disposiciones de este Real Decreto y la normativa autonómica.
Los únicos residuos que pueden ser valorizados a través de una operación R1001 con el fin de aplicarse a los suelos agrarios son los que se incluyen en el Anexo VIII.
ANEXO VIII
Materiales distintos de productos fertilizantes y estiércoles que pueden emplearse en la fertilización de los suelos agrarios
Parte 1. Lista de materiales que pueden emplearse en la fertilización de los suelos agrarios
1. Con excepción de los productos fertilizantes, los estiércoles sin tratar, los subproductos de origen animal no aptos para el consumo humano incluidos en el artículo 11 del Real Decreto 1528/2012, de 8 de noviembre, la paja y otros materiales naturales, agrícolas o silvícolas, no peligrosos, utilizados en explotaciones agrícolas y ganaderas y en la silvicultura, mediante procedimientos o métodos que no pongan en peligro la salud humana o dañen el medio ambiente, y que están excluidos específicamente del ámbito de aplicación de la Ley 7/2022, de 8 de abril, sólo podrán incorporarse a los suelos agrarios los materiales que figuren en la lista siguiente:
a) Materiales que, sin haberse empleado en la elaboración de un producto fertilizante, cumplan con todos los requisitos de las CMCS 3, 4, 5, 6, 12, 13 y 14 del anexo II del Reglamento (UE) 2019/1009.
b) Subproductos de origen animal no aptos para consumo humano, que hayan sido tratados conforme al artículo 20 del Reglamento (CE) 1069/2009.
c) Compost de alperujo.
d) Alperujo desecado.
e) Lodos de tratamiento de aguas residuales urbanas (lodos EDAR), incluidos en el Real Decreto 1310/1990, de 29 de octubre. siempre que hayan sido tratados.
f) Lodos calizos procedentes del proceso Kraft de fabricación de pasta de papel, para elevar el pH de suelos ácidos.
2. La inclusión de un residuo en esta lista no le exime de cumplir lo establecido en la Ley 7/2022, de 8 de abril, y en particular, lo establecido en los artículos 33 y 65, relativos a las autorizaciones y obligaciones de información.
3. La inclusión de un subproducto animal no apto para consumo humano en esta lista no le exime de cumplir con lo establecido en el Reglamento (CE) 1069/2009.
4. Los materiales que se apliquen al suelo agrario deberán cumplir, además, con los requisitos de la parte 2 del presente anexo que les sean de aplicación.
El Real Decreto prevé que se puedan incluir nuevos residuos en el Anexo VIII, pudiendo proceder la iniciativa de los departamentos ministeriales, de los órganos competentes de las comunidades autónomas o a petición de los operadores, sus asociaciones o cualquier otro interesado.
Para iniciar la solicitud, los interesados deberán presentar la correspondiente propuesta a la Dirección General de Producciones y Mercados Agrarios, acompañada de un expediente técnico justificativo de la citada modificación en el que el interesado deberá demostrar:
a) Que tiene eficacia agronómica, en particular, que puede emplearse para mejorar o proteger las propiedades físicas o químicas, la estructura o la actividad biológica del suelo al que se añade, o para aportar nutrientes a los vegetales u hongos que se desarrollen en dicho suelo.
b) Que se dispone, para el residuo, de métodos adecuados de toma de muestras, de análisis y de ensayo para poder comprobar sus riquezas y cualidades, así como los posibles contaminantes que por su origen y método de obtención puedan ser preocupantes.
c) Que, en condiciones normales de uso, no produzca efectos perjudiciales para la salud, el medio ambiente, el suelo agrario al que se pretende aplicar, los cultivos que se vayan a desarrollar en él o el ganado que pueda entrar en contacto con dicho residuo cuando se emplee en agricultura.
Respecto a la aplicación de los residuos valorizables a los suelos agrarios, el Real Decreto establece su aplicación únicamente en tierras sin cultivo implantado, y cuando se apliquen en plantaciones leñosas o en cultivos herbáceos permanentes como la platanera y la papaya, se hará directamente al suelo y antes del fin de la parada invernal. En el caso de las praderas permanentes se podrán aplicar previa autorización de la comunidad autónoma.